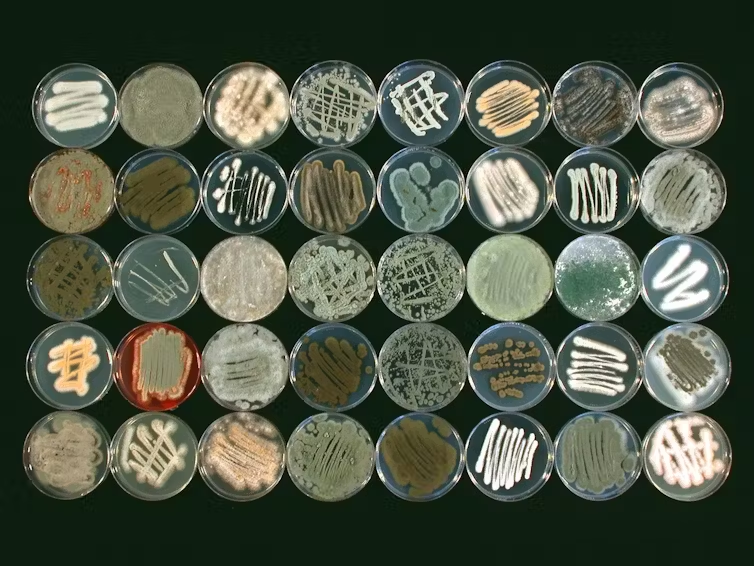

Los hongos están en todas partes y, sin embargo, son muy poco comprendidos. No son ni plantas ni animales. Así, junto a los reinos vegetal y animal, forman su propio reino que alberga una gran riqueza de especies y formas de vida. Desempeñan un papel fundamental en el funcionamiento de los ecosistemas y para los seres humanos. Muchos hongos, por ejemplo, participan en la descomposición de la materia orgánica, lo que permite el reciclaje de la materia haciendo que los nutrientes vuelvan a ser accesibles a las plantas.
Muchos de ellos también se asocian con las plantas intercambiando directamente nutrientes para beneficio mutuo. Otros son comestibles o se utilizan para la producción de bebidas y alimentos mediante fermentación. Algunos incluso tienen la capacidad de extraer contaminantes del suelo a través de un proceso llamado biorremediación o micorremediación.

CC BY
Decir cuántas especies de hongos existen es una tarea difícil, porque una gran proporción no son visibles a simple vista. Muchos no son cultivables en el laboratorio, lo que hace aún más compleja su identificación y descripción. Hoy en día se conocen 155.000 especies, pero algunos estudios estiman que quedan entre 2 y 4 millones de especies de hongos por descubrir e identificar.
¿Qué es un hongo?
Pero ¿qué es exactamente un hongo? ¡Gran pregunta! De hecho, la palabra «seta» se asocia a menudo a la imagen de la estructura que emerge del suelo, con su tallo y su sombrero, o bien unida a un árbol, en forma de espiga. Sin embargo, la mayoría de las especies de hongos no producen este tipo de estructuras. En las especies que lo tienen, esta parte del hongo contiene las esporas sexuales. Su nombre científico es “esporóforo”. En inglés, esta distinción aparece, ya que hay dos palabras distintas: «seta», que describe los esporóforos, es decir esta parte presente en ciertos hongos, y «fungus», que describe todas las especies pertenecientes a la clase Fungi.
El resto del cuerpo del hongo rara vez es visible y es muy distintivo. Es una red microscópica formada por hifas. Estas hifas son células muy alargadas que forman una especie de túnel de unas pocas micras de diámetro. Su conjunto ramificado, llamado “micelio”, se desarrolla en el sustrato sobre el que crece (en el suelo, sobre madera, sobre hojas muertas, etc.) para buscar y extraer nutrientes.
Un hongo es por tanto un organismo unicelular (como la levadura) o multicelular que se caracteriza por una pared celular que contiene quitina y células reproductoras no móviles (llamadas esporas).
No es una planta por muchas razones: los hongos no hacen la fotosíntesis y no tienen savia. La pared celular de las plantas está hecha de celulosa, no de quitina.
Interesarse por los hongos significa adentrarse en lo infinitamente pequeño pero también en lo infinitamente grande. Así, a finales de la década de 1980, unos científicos descubrieron en Oregón (noroeste de Estados Unidos) un ejemplar de Armillaria gallica de casi 2.500 años de antigüedad cuyo micelio se extendía por más de 37 hectáreas.
CC BY
Una lista roja creciente
Para saber cuántos hongos están amenazados, debemos consultar la Lista Roja de la UICN (Unión Internacional para la Conservación de la Naturaleza). Es el inventario más completo, que enumera las especies y su estado de conservación. Su primera edición fue publicada en 1964. En ese caso, sólo contiene mamíferos y aves raros.
En lo que respecta a las setas en Francia, habrá que esperar hasta 2024 para que el comité francés de la UICN publique el primer inventario de setas amenazadas.
El 27 de marzo, la Lista Roja mundial se actualizó para incluir el estado de 1.300 especies de hongos. Estamos lejos de las 155.000 especies conocidas, pero las evaluaciones iniciales siguen siendo preocupantes con 411 especies de hongos amenazadas de extinción, o casi un tercio de las especies registradas.
Si bien esta cifra es significativa, es importante recordar que, debido a la falta de información, se listaron primero las especies consideradas más vulnerables para facilitar el desarrollo de proyectos de conservación.
Algunas de estas especies son raras y sólo se han detectado en áreas geográficas muy restringidas. En Francia metropolitana y Córcega, la lista roja se extiende a 79 especies amenazadas y 39 especies con estatus «casi amenazadas». Esta lista incluye líquenes, entre ellos Buellia asterella, clasificada en peligro crítico de extinción, que no se ha encontrado en el territorio desde 1960. También hay hongos descomponedores, como Laccariopsis mediterranea, que crece en las dunas costeras del Mediterráneo y cuyas poblaciones están en fuerte declive (aproximadamente un 30% en los últimos treinta años).
Algunas especies forman relaciones simbióticas con las plantas: las plantas proporcionan azúcares de la fotosíntesis, mientras que los hongos proporcionan nutrientes del suelo. Estas especies también están amenazadas; por ejemplo, Cortinarius prasinocyaneus, un hongo asociado con el roble y el carpe. En Francia, sólo aparece en cinco sitios.
Amenazas bien identificadas, repercusiones mucho menores
Aunque el mundo de los hongos sigue siendo poco conocido en muchos aspectos, al igual que el número exacto de especies vulnerables, una cosa es segura: las amenazas a estas especies están bien identificadas. Hay cambios en el uso del suelo, en particular con la destrucción de hábitats y la deforestación, la contaminación vinculada a la urbanización y la agricultura (fertilización y pesticidas irrazonables). El cambio climático se suma ahora a otras amenazas que enfrentan los hongos.
Su pérdida podría provocar cambios en el funcionamiento de los ecosistemas. Muchos hongos participan en la descomposición, un proceso importante en el ciclo de nutrientes. En el caso de las especies que forman relaciones simbióticas con plantas, estas asociaciones pueden ser muy específicas y los hongos sólo pueden asociarse con una o dos especies de árboles. Es el caso de Geomorium gamundiae en Argentina y Destuntzia rubra en China y Japón, especies en peligro crítico de extinción debido a la deforestación que amenaza a su planta hospedante.
Pero también podría ocurrir lo contrario: si el hongo se viera amenazado, tendría consecuencias perjudiciales para su huésped.
Conservación de hongos: aún queda un largo camino por recorrer
A diferencia de la flora y la fauna, no existe un plan de conservación para las especies de hongos.
Dado que el conocimiento sobre estos organismos era demasiado limitado para incluirlos en las leyes ambientales cuando surgieron, fueron en gran medida olvidados en los proyectos de conservación. Actualmente, la única protección para estas especies es la protección y conservación de los hábitats, a través de directivas como la red Natura 2000 en la Unión Europea.
Sin embargo, existen iniciativas para promover la investigación, el conocimiento y la inclusión de los hongos en la legislación. Debido a su ubicuidad y sus funciones en el ecosistema, los hongos forman un reino tan importante como las plantas o los animales.
Por ello es fundamental tenerlos en cuenta para proteger los ecosistemas integrando la fauna, la flora… y los hongos.
Fuente: theconversation.com